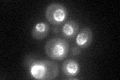
YPL169C
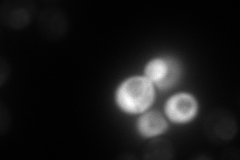
YPL169C
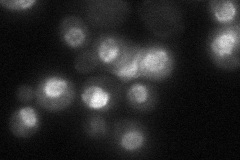
YPL169C
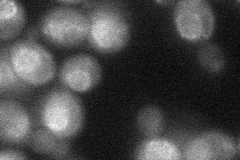
YPL169C
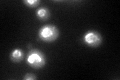
YPL169C
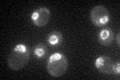
YPL169C

View description
Poly(A)RNA binding protein involved in nuclear mRNA export, component of the nuclear pore; ortholog of human TAP
Localization:
Intensity:
Fold change:
Significance:
-
C’ GFP library in SD
nuclear periphery60.94 -
N' NOP1pr-GFP in SD

punctate,nuclear periphery72.4527 -
N' TEF2pr-mCherry in SD
punctate,nuclear periphery55.4257 -
N' NATIVEpr-GFP in SD
punctate,nuclear periphery20.9137 -
N' TEF2pr-VC and Cyto-VN in SD
nuclear periphery37.9003 -
C’ GFP library in SD+DTT
nuclear periphery66.481.09No -
C’ GFP library in SD+H2O2

nuclear periphery61.761.01No -
C’ GFP library in Starvation Media
nuclear periphery47.260.77No -
C’ GFP library on the background of Pup2-DaMP

nuclear periphery -
C’ GFP library on the background of CCT mutant

nuclear periphery61.8581.01486No
